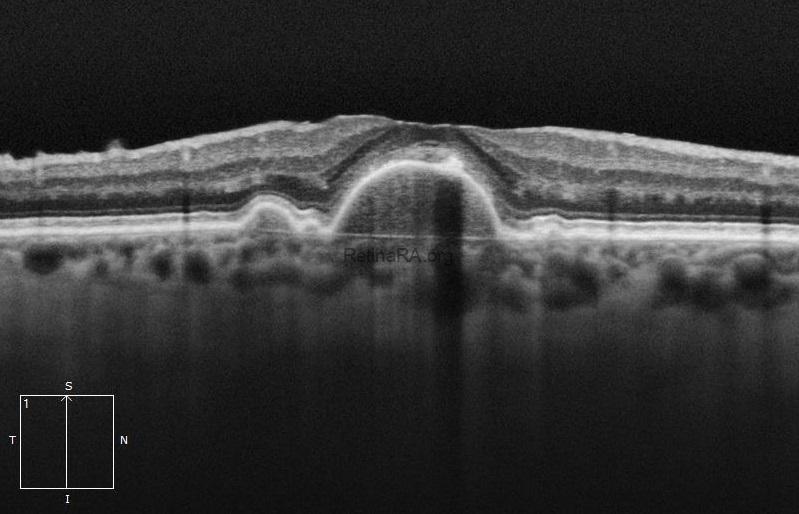

Drusen may grow and coalesce to form drusenoid pigment epithelial detachment (PED). Although there is no definitively accepted value, drusen larger than 350 microns have been accepted as drusenoid PED in some clinical studies. On color fundus photography, the Drusenoid PED appears as a large yellow, raised area above the surface. RPE proliferation may accompany. OCT provides a definitive diagnosis of drusenoid PED. Note that hyperreflectivity of drusen and drusenoid PED are same. RPE proliferation, seen as a gray-brown area within the drusenoid PED on color photography, is observed as a hyperreflective formation at the level of the RPE causing shadowing underneath on OCT.
Credit: M. Giray Ersoz, MD, FEBO
Biruni University School of Medicine, Department of Ophthalmology, Istanbul, Turkey
Instagram accounts: @retina.review and @retina.dr.girayersoz
Color photography of drusenoid PED

 OCT of drusenoid PED
OCT of drusenoid PED


 OCT of drusenoid PED
OCT of drusenoid PED


 OCT of drusenoid PED
OCT of drusenoid PED